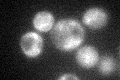
YLR459W

View description
GPI transamidase subunit, involved in attachment of glycosylphosphatidylinositol (GPI) anchors to proteins; may have a role in recognition of the attachment signal or of the lipid portion of GPI
Localization:
Intensity:
Fold change:
Significance:
-
C’ GFP library in SD

ER27.01 -
N' NOP1pr-GFP in SD

ER97.0444 -
N' TEF2pr-mCherry in SD

missing0 -
N' NATIVEpr-GFP in SD

missing0 -
N' TEF2pr-VC and Cyto-VN in SD

#N/A0 -
C’ GFP library in SD+DTT

ER27.061No -
C’ GFP library in SD+H2O2
ER25.250.93No -
C’ GFP library in Starvation Media

ER24.240.89No -
C’ GFP library on the background of Pup2-DaMP

ER -
C’ GFP library on the background of CCT mutant

ER17.75270.657038Yes
